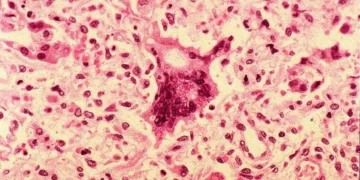
Sarampo atinge o nível mais elevado de casos na Europa em mais de 25 anos

A Romênia é um país europeu que, como muitos outros, foi afetado pela pandemia do novo coronavírus. No entanto, recentemente, o país ganhou destaque na mídia internacional por um motivo preocupante: registrou mais de 30 mil infecções, se tornando o país com mais casos na Europa.
Essa notícia, sem dúvida, é preocupante e traz à tona a importância de seguir as medidas de prevenção e controle da doença. No entanto, é importante ressaltar que a Romênia não está sozinha nessa luta e que o país está tomando medidas eficazes para combater a propagação do vírus.
Desde o início da pandemia, o governo romeno tem adotado medidas rigorosas para conter o avanço do vírus, como o fechamento de fronteiras, a implementação de quarentenas e o uso obrigatório de máscaras em locais públicos. Além disso, foram realizados esforços para aumentar a capacidade de testes e tratamento da doença.
Essas medidas têm mostrado resultados positivos, já que a Romênia tem uma taxa de mortalidade relativamente baixa em comparação com outros países europeus. Isso se deve, em grande parte, à estrutura do sistema de saúde do país, que tem se mostrado eficiente no enfrentamento da pandemia.
Além disso, é importante destacar que a Romênia tem uma população de mais de 19 milhões de habitantes, o que faz com que o número de casos registrados seja proporcional ao tamanho da população. Além disso, a maioria dos casos está concentrada em áreas mais populosas, como a capital Bucareste, o que reforça a necessidade de medidas de distanciamento social.
Outro fator que deve ser considerado é que a Romênia é um país que tem uma economia em desenvolvimento e, como muitos outros, enfrenta desafios em relação ao acesso à saúde e à infraestrutura. No entanto, mesmo diante dessas dificuldades, o país tem se esforçado para garantir a assistência médica necessária aos pacientes com COVID-19.
Além disso, a Romênia tem buscado soluções criativas para enfrentar a crise econômica causada pela pandemia. O governo lançou um pacote de medidas de estímulo à economia, que inclui ajuda financeira para pequenas empresas e incentivos fiscais para a manutenção de empregos. Essas ações são essenciais para garantir a sobrevivência das empresas e a manutenção dos empregos em um momento tão desafiador.
Também é importante mencionar que a Romênia tem recebido apoio da União Europeia e de outros países para enfrentar a pandemia. A UE disponibilizou recursos financeiros e equipamentos médicos para ajudar no combate à doença. Além disso, a solidariedade entre os países europeus tem sido fundamental para superar esse momento difícil.
É importante ressaltar que a situação atual da Romênia não é motivo para pânico, mas sim para atenção e ação. O país tem registrado uma diminuição no número de novos casos diários e, com as medidas de prevenção e controle sendo seguidas, é possível conter a propagação do vírus.
Portanto, é fundamental que a população romena continue seguindo as recomendações das autoridades de saúde, como o distanciamento social, a higiene das mãos e o uso de máscaras. Essas medidas são essenciais para proteger a si mesmo e aos outros.
É importante também que a mídia e a população em geral não se concentrem apenas nos números de casos, mas também nas ações que estão sendo tomadas para combater a pandemia. A Romênia tem mostrado resiliência e determinação para superar esse momento difícil e, com o apoio de todos, com cert